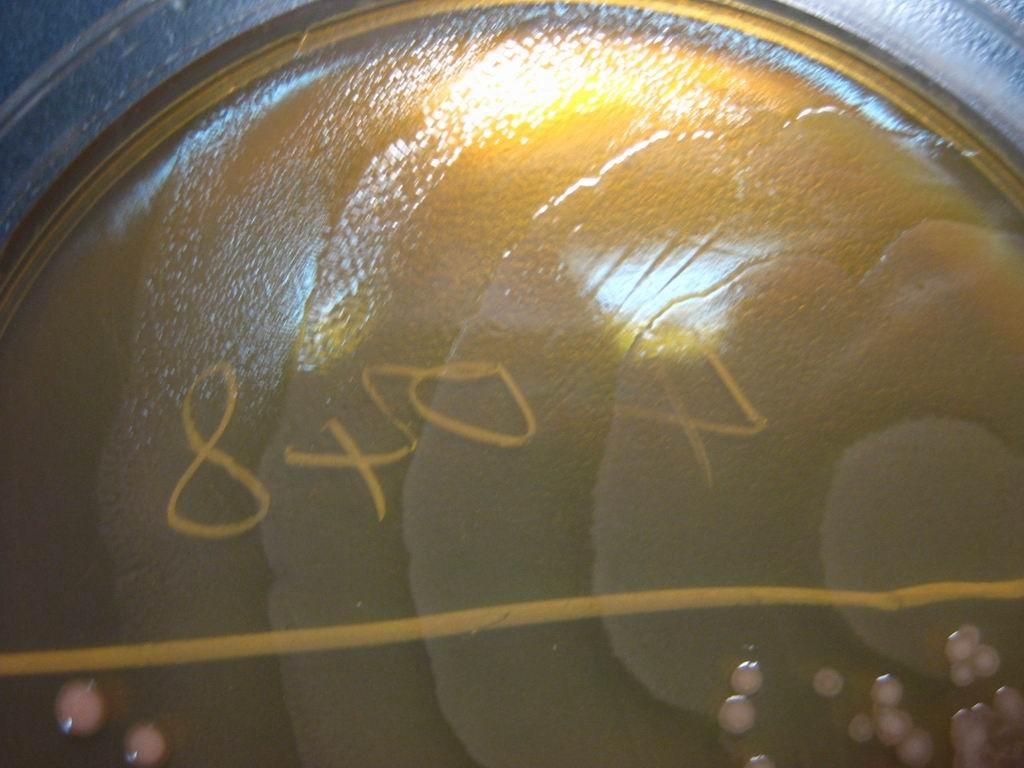
【原创图片】看图识菌——考考您的眼力2-变形杆菌

变形杆菌图片显微镜

奇异变形杆菌图册_360百科
图片尺寸2048x1536
普通变形杆菌
图片尺寸365x223
没冲干净的变形链球菌#臣妾真的染不好色吗
图片尺寸1260x1680
变形杆菌属
图片尺寸1600x1200
变形杆菌属
图片尺寸268x201
普通变形杆菌和奇异变形杆菌的检验
图片尺寸1000x1000
在显微镜下变形菌门
图片尺寸700x572
变形菌门
图片尺寸290x232
普通变形杆菌-北纳生物
图片尺寸417x556
【原创图片】看图识菌——考考您的眼力2-变形杆菌
图片尺寸1024x768
转载认识变形菌门变形菌门扩张的原因和健康风险
图片尺寸300x283
变形杆菌属寻常的细菌
图片尺寸1100x1100
亲手分离出的奇异变形杆菌
图片尺寸1080x1080
变形链球菌
图片尺寸750x562
变形杆菌属的救治原则
图片尺寸408x419
cn113080461a_一种具有抑制奇异变形杆菌生长作用的益生菌及其发酵液
图片尺寸946x924
【慧眼识菌】变形杆菌身后的"红魔"
图片尺寸1280x720
奇异变形杆菌
图片尺寸377x213
(图片来源:网络)变形杆菌还广泛分布在土壤中,是人们极易感染的细菌
图片尺寸856x900
普通变形杆菌
图片尺寸300x184